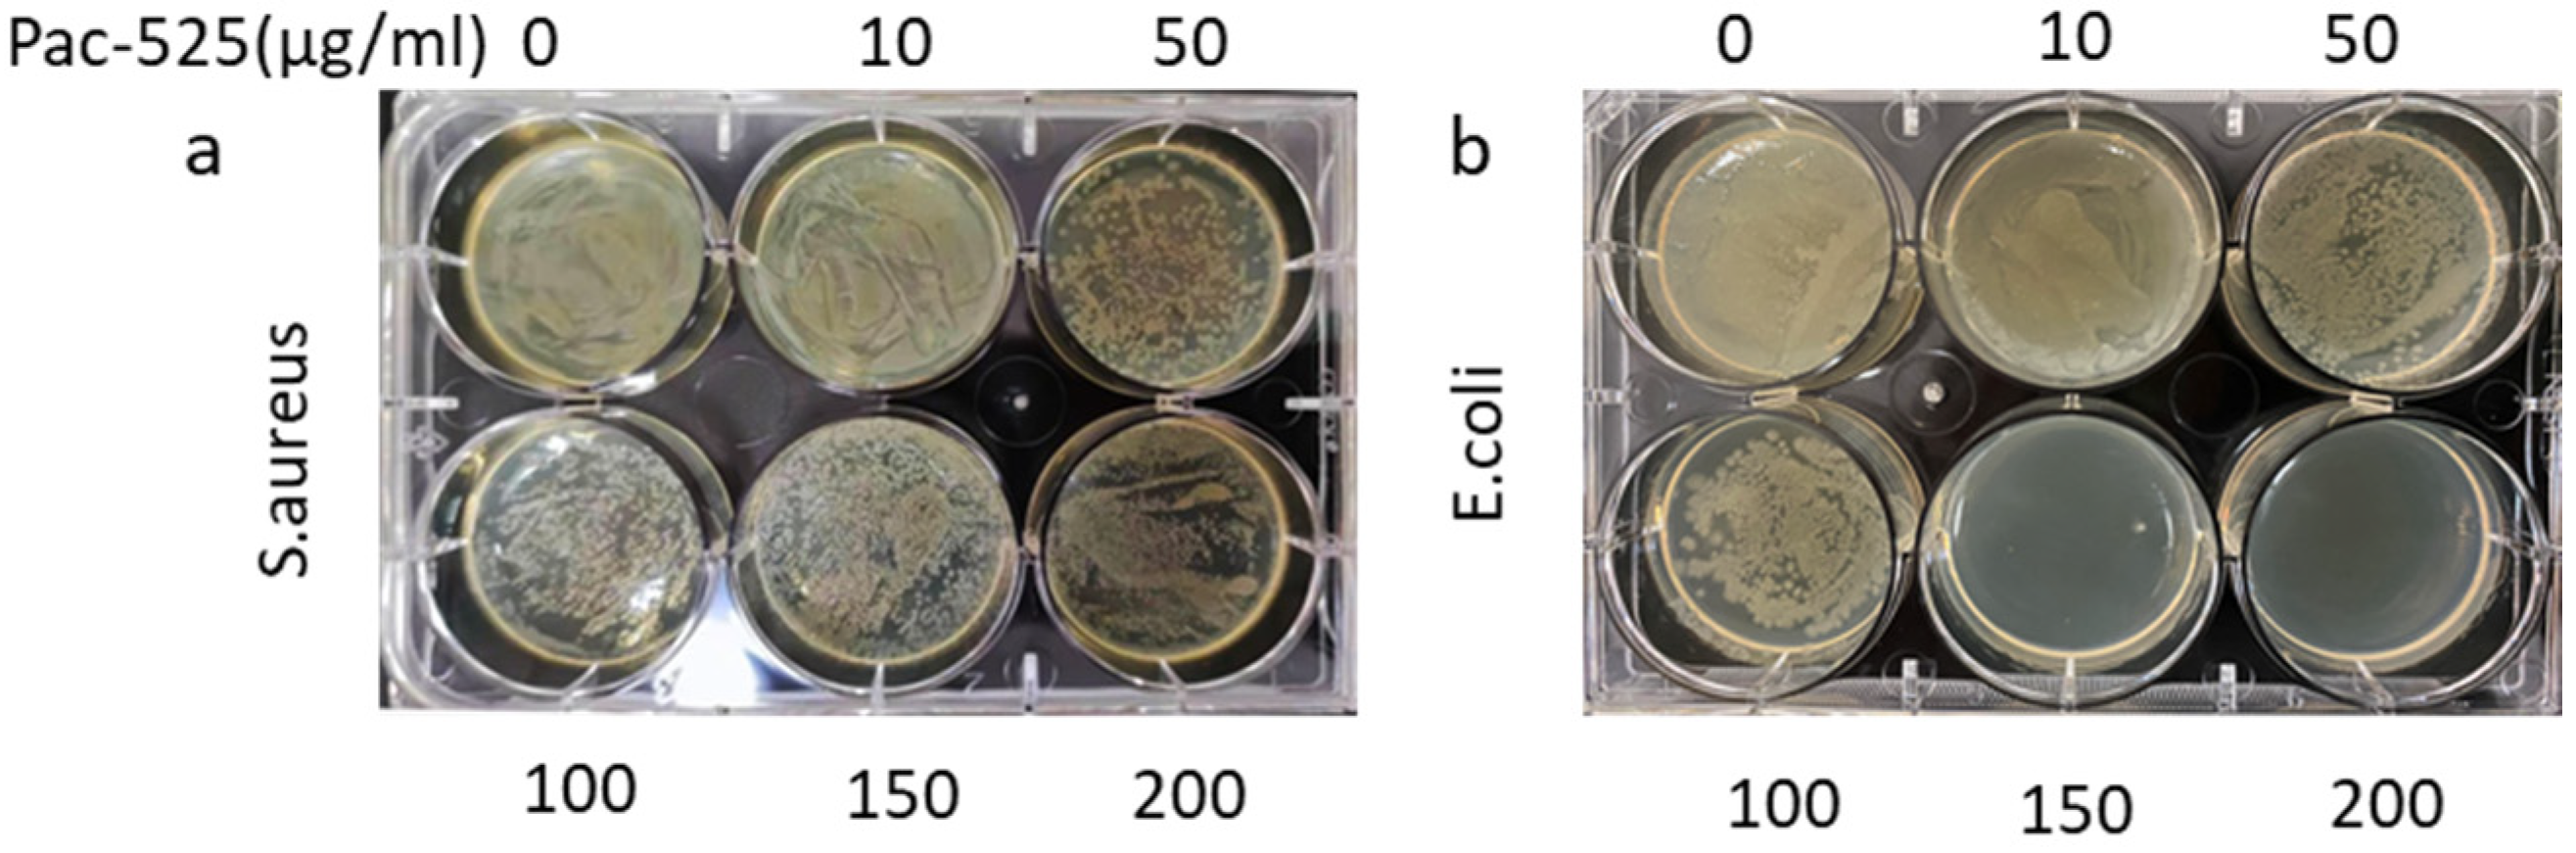
Nanomaterials 11 03306 g005

A Novel Antibacterial Titanium Modification with a Sustained Release of Pac-525
Abstract
:1. Introduction
2. Materials and Methods
2.1. Preparation of Pac@PLGA MS/HA Coated Ti
2.2. Phase Composition Analysis
2.3. Morphology Analysis
2.4. Release Curve Analysis
2.5. The Biocompatibility of Pac-525 and Pac@PLGA MS/HA Coated Ti
2.5.1. Cell Viability
2.5.2. Cell Adhesion and Proliferation
2.6. Antibacterial Activity of Pac@PLGA MS/HA Coated Ti
2.6.1. Antibacterial Activity Test of Pac-525
2.6.2. Antibacterial Function of Pac@PLGA MS/HA Coated Ti
3. Results
3.1. Characterization of Pac@PLGA MS/HA Coated Ti
3.2. Release Curve of Pac@PLGA MS/HA Coated Ti
3.3. Biocompatibility of Pac-525 and Pac@PLGA MS/HA Coated Ti
3.4. Antimicrobial Capability of Pac-525 and Pac@PLGA MS/HA Coated Ti
4. Discussion
5. Conclusions
Supplementary Materials
Author Contributions
Funding
Data Availability Statement
Acknowledgments
Conflicts of Interest
References
- Chouirfa, H.; Bouloussa, H.; Migonney, V.; Falentin-Daudré, C. Review of titanium surface modification techniques and coatings for antibacterial applications. Acta Biomater. 2018, 83, 37–54. [Google Scholar] [CrossRef]
- Kobayashi, M.; Nihonmatsu, S.; Okawara, T.; Onuki, H.; Sakagami, H.; Nakajima, H.; Takeishi, H.; Shimada, J. Adhesion and Proliferation of Osteoblastic Cells on Hydroxyapatite-dispersed Ti-based Composite Plate. In Vivo 2019, 33, 1067–1079. [Google Scholar] [CrossRef] [PubMed] [Green Version]
- Xuereb, M.; Camilleri, J.; Attard, N.J. Systematic review of current dental implant coating materials and novel coating techniques. Int. J. Prosthodont. 2015, 28, 51–59. [Google Scholar] [CrossRef] [Green Version]
- Ong, J.; Chan, D.C.N. A Review of Hydroxapatite and its use as a Coating in Dental Implants. Crit. Rev. Biomed. Eng. 2017, 45, 411–451. [Google Scholar] [CrossRef]
- Asri, R.I.M.; Harun, W.S.W.; Hassan, M.A.; Ghani, S.A.C.; Buyong, Z. A review of hydroxyapatite-based coating techniques: Sol–gel and electrochemical depositions on biocompatible metals. J. Mech. Behav. Biomed. Mater. 2016, 57, 95–108. [Google Scholar] [CrossRef] [Green Version]
- Yavari, S.A.; van der Stok, J.; Chai, Y.C.; Wauthle, R.; Birgani, Z.T.; Habibovic, P.; Mulier, M.; Schrooten, J.; Weinans, H.; Zadpoor, A.A. Bone regeneration performance of surface-treated porous titanium. Biomaterials 2014, 35, 6172–6181. [Google Scholar] [CrossRef]
- Beirne, O. Reaction to the symposium, Hydroxyapatite coating on dental implants: Benefits and risks. J. Oral Implantol. 1994, 20, 240–243. [Google Scholar]
- Ozawa, S.; Kasugai, S. Evaluation of implant materials (hydroxyapatite, glass-ceramics, titanium) in rat bone marrow stromal cell culture. Biomaterials 1996, 17, 23–29. [Google Scholar] [CrossRef]
- Mouhyi, J.; Ehrenfest, D.M.D.; Albrektsson, T. The Peri-Implantitis: Implant Surfaces, Microstructure, and Physicochemical Aspects. Clin. Implant. Dent. Relat. Res. 2009, 14, 170–183. [Google Scholar] [CrossRef]
- Lischer, S.; Körner, E.; Balazs, D.J.; Shen, D.; Wick, P.; Grieder, K.; Haas, D.; Heuberger, M.; Hegemann, D. Antibacterial burst-release from minimal Ag-containing plasma polymer coatings. J. R. Soc. Interface 2011, 8, 1019–1030. [Google Scholar] [CrossRef] [PubMed]
- Broggini, N.; McManus, L.M.; Hermann, J.S.; Medina, R.; Schenk, R.K.; Buser, D.; Cochran, D.L. Peri-implant inflammation defined by the implant-abutment interface. J. Dent. Res. 2006, 85, 473–478. [Google Scholar] [CrossRef]
- Cloutier, M.; Mantovani, D.; Rosei, F. Antibacterial Coatings: Challenges, Perspectives, and Opportunities. Trends Biotechnol. 2015, 33, 637–652. [Google Scholar] [CrossRef] [PubMed]
- Asri, R.I.M.; Harun, W.S.W.; Samykano, M.; Lah, N.A.C.; Ghani, S.A.C.; Tarlochan, F.; Raza, M.R. Corrosion and surface modification on biocompatible metals: A review. Mater. Sci. Eng. C Mater. Biol. Appl. 2017, 77, 1261–1274. [Google Scholar] [CrossRef] [Green Version]
- Müller, R.; Abke, J.; Schnell, E.; Scharnweber, D.; Kujat, R.; Englert, C.; Taheri, D.; Nerlich, M.; Angele, P. Influence of surface pretreatment of titanium- and cobalt-based biomaterials on covalent immobilization of fibrillar collagen. Biomaterials 2006, 27, 4059–4068. [Google Scholar] [CrossRef] [PubMed]
- Qin, S.; Xu, K.; Nie, B.; Ji, F.; Zhang, H. Approaches based on passive and active antibacterial coating on titanium to achieve antibacterial activity. J. Biomed. Mater. Res. Part A 2018, 106, 2531–2539. [Google Scholar] [CrossRef]
- Wang, J.; Helder, L.; Shao, J.; Jansen, J.A.; Yang, M.; Yang, F. Encapsulation and release of doxycycline from electrospray-generated PLGA microspheres: Effect of polymer end groups. Int. J. Pharm. 2019, 564, 1–9. [Google Scholar] [CrossRef]
- Hsu, M.Y.; Huang, Y.-T.; Weng, C.-J.; Chen, C.-M.; Su, Y.-F.; Chu, S.-Y.; Tseng, J.-H.; Wu, R.-C.; Liu, S.-J. Preparation and in vitro/in vivo evaluation of doxorubicin-loaded poly[lactic-co-glycol acid] microspheres using electrospray method for sustained drug delivery and potential intratumoral injection. Colloids Surf. B Biointerfaces 2020, 190, 110937. [Google Scholar] [CrossRef] [PubMed]
- Danhier, F.; Ansorena, E.; Silva, J.M.; Coco, R.; le Breton, A.; Préat, V. PLGA-based nanopar-ticles: An overview of biomedical applications. J. Control. Release 2012, 161, 505–522. [Google Scholar] [CrossRef] [PubMed]
- Schaer, T.P.; Stewart, S.; Hsu, B.B.; Klibanov, A.M. Hydrophobic polycationic coatings that inhibit biofilms and support bone healing during infection. Biomaterials 2012, 33, 1245–1254. [Google Scholar] [CrossRef]
- Yao, S.; Liu, H.; Yu, S.; Li, Y.; Wang, X.; Wang, L. Drug-nanoencapsulated PLGA micro-spheres prepared by emulsion electrospray with controlled release behavior. Regen. Biomater. 2016, 3, 309–317. [Google Scholar] [CrossRef] [Green Version]
- Costa, F.; Carvalho, I.F.; Montelaro, R.C.; Gomes, P.; Martins, M.C.L. Covalent immobilization of antimicrobial peptides (AMPs) onto biomaterial surfaces. Acta Biomater. 2011, 7, 1431–1440. [Google Scholar] [CrossRef] [Green Version]
- Lakshmaiah Narayana, J.; Chen, J.-Y. Antimicrobial peptides: Possible anti-infective agents. Peptides 2015, 72, 88–94. [Google Scholar] [CrossRef]
- Onaizi, S.A.; Leong, S.S. Tethering antimicrobial peptides: Current status and potential challenges. Biotechnol. Adv. 2011, 29, 67–74. [Google Scholar] [CrossRef]
- Li, Y.Y.; Na, R.W.; Wang, X.M.; Liu, H.Y.; Zhao, L.Y.; Sun, X.D.; Ma, G.W.; Cui, F.Z. Fabrication of Antimicrobial Peptide-Loaded PLGA/Chitosan Composite Microspheres for Long-Acting Bacterial Resistance. Molecules 2017, 22, 1637. [Google Scholar] [CrossRef] [Green Version]
- Li, J.Y.; Wang, X.J.; Wang, L.N.; Ying, X.X.; Ren, X.; Liu, H.Y.; Xu, L.; Ma, G.W. High in vitro antibacterial activity of Pac-525 against Por-phyromonas gingivalis biofilms cultured on titanium. Biomed. Res. Int. 2015, 2015, 1–8. [Google Scholar]
- He, Y.; Jin, Y.; Wang, X.; Yao, S.; Li, Y.; Wu, Q.; Ma, G.; Cui, F.; Liu, H. An Antimicrobial Peptide-Loaded Gelatin/Chitosan Nanofibrous Membrane Fabricated by Sequential Layer-by-Layer Electrospinning and Electrospraying Techniques. Nanomaterials 2018, 8, 327. [Google Scholar] [CrossRef] [Green Version]
- Wang, S.; Yang, Y.; Wang, R.; Kong, X.; Wang, X. Mineralization of calcium phosphate controlled by biomimetic self-assembled peptide monolayers via surface electrostatic potentials. Bioact. Mater. 2020, 5, 387–397. [Google Scholar] [CrossRef] [PubMed]
- Hamouda, I.M.; Enan, E.T.; Al-Wakeel, E.E.; Yousef, M.K.M. Alkali and heat treatment of titanium implant material for bioactivity. Int. J. Oral Maxillofac. Implant. 2012, 27, 776–784. [Google Scholar]
- Kawai, T.; Takemoto, M.; Fujibayashi, S.; Tanaka, M.; Akiyama, H.; Nakamura, T.; Matsuda, S. Comparison between alkali heat treatment and sprayed hydroxyapatite coating on thermally-sprayed rough Ti surface in rabbit model: Effects on bone-bonding ability and osteoconductivity. J. Biomed. Mater. Res. Part B Appl. Biomater. 2014, 103, 1069–1081. [Google Scholar] [CrossRef] [PubMed] [Green Version]
- Shin, K.; Acri, T.; Geary, S.; Salem, A.K. Biomimetic Mineralization of Biomaterials Using Simulated Body Fluids for Bone Tissue Engineering and Regenerative Medicine. Tissue Eng. Part A 2017, 23, 1169–1180. [Google Scholar] [CrossRef] [PubMed]
- Moravej, H.; Moravej, Z.; Yazdanparast, M.; Heiat, M.; Mirhosseini, A.; Moghaddam, M.M.; Mirnejad, R. Antimicrobial Peptides: Features, Action, and Their Resistance Mechanisms in Bacteria. Microb. Drug Resist. 2018, 24, 747–767. [Google Scholar] [CrossRef] [PubMed]
- Zhang, J.; Zhu, W.H.; Xin, B.K.; Lin, S.; Jin, L.B.; Wang, H.Y. Development of an antibacterial surface with a self-defensive and pH-responsive function. Biomater. Sci. 2019, 7, 3795–3800. [Google Scholar] [CrossRef]
- Aranya, A.K.; Pushalkar, S.; Zhao, M.; LeGeros, R.Z.; Zhang, Y.; Saxena, D. Antibacterial and bioactive coatings on titanium implant surfaces. J. Biomed. Mater. Res. Part A 2017, 105, 2218–2227. [Google Scholar] [CrossRef] [Green Version]
- Kapoor, D.N.; Bhatia, A.; Kaur, R.; Sharma, R.; Kaur, G.; Dhawan, S. PLGA: A unique polymer for drug delivery. Ther. Deliv. 2015, 6, 41–58. [Google Scholar] [CrossRef] [PubMed]
- Xu, Y.; Kim, C.-S.; Saylor, D.M.; Koo, D. Polymer degradation and drug delivery in PLGA-based drug-polymer applications: A review of experiments and theories. J. Biomed. Mater. Res. Part B Appl. Biomater. 2016, 105, 1692–1716. [Google Scholar] [CrossRef]

Publisher’s Note: MDPI stays neutral with regard to jurisdictional claims in published maps and institutional affiliations. |
© 2021 by the authors. Licensee MDPI, Basel, Switzerland. This article is an open access article distributed under the terms and conditions of the Creative Commons Attribution (CC BY) license (https://creativecommons.org/licenses/by/4.0/).
Share and Cite
He, Y.; Li, Y.; Zuo, E.; Chai, S.; Ren, X.; Fei, T.; Ma, G.; Wang, X.; Liu, H. A Novel Antibacterial Titanium Modification with a Sustained Release of Pac-525. Nanomaterials 2021, 11, 3306. https://doi.org/10.3390/nano11123306
He Y, Li Y, Zuo E, Chai S, Ren X, Fei T, Ma G, Wang X, Liu H. A Novel Antibacterial Titanium Modification with a Sustained Release of Pac-525. Nanomaterials. 2021; 11(12):3306. https://doi.org/10.3390/nano11123306
Chicago/Turabian StyleHe, Yuzhu, Yuanyuan Li, Enjun Zuo, Songling Chai, Xiang Ren, Tao Fei, Guowu Ma, Xiumei Wang, and Huiying Liu. 2021. "A Novel Antibacterial Titanium Modification with a Sustained Release of Pac-525" Nanomaterials 11, no. 12: 3306. https://doi.org/10.3390/nano11123306






